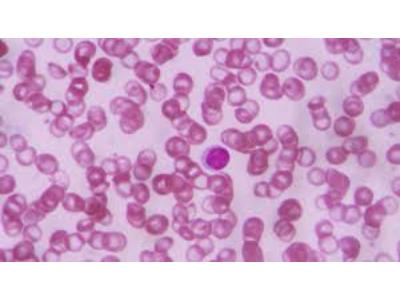

Press release
Sickle Cell Disease Diagnosis Market Size to Hit $7.9 Billion by 2028 | Sickle Cell Disease Diagnosis Industry Forecast Report
According to our experience research team, Sickle Cell Disease Diagnosis Market was valued at USD 1.4 Billion in 2021, and the global Sickle Cell Disease Diagnosis industry is projected to reach a value of USD 7.9 Billion by 2028, at a CAGR of 7.8% during the forecast period 2022-2028The report is focused on gaining various Sickle Cell Disease Diagnosis market trends, dynamics, growth drivers, opportunities, weaknesses, strengths, and threats restraining the market growth. Further, the global Sickle Cell Disease Diagnosis industry report offers detailed visions of various growth opportunities and challenges based on various types of products, end users, applications, and countries, among others.
The research process involved the study of various factors affecting the industry, including the market situation, government policy, historical data, competitive landscape, and present trends in the Sickle Cell Disease Diagnosis market, upcoming technologies, technological innovation, and the technical progress in related Sickle Cell Disease Diagnosis industry.
Get Immediate Access to Our Free Sample Report@ https://www.vantagemarketresearch.com/sickle-cell-disease-diagnosis-market-0209/request-sample
Competitive Landscape:
Comprehensive company profiles give visions into their recent market activities, supply chain analysis, revenue information, financial strategies, product offerings, market size, and share and sales strategies.
List of Leading Players in the Sickle Cell Disease Diagnosis Market:
Alpha Labs, Atlas Medical, BioMedomics Inc, Mayo Clinic, Fisher Scientific, Cigna, ASI, Silver Lake, Research Corporation, LABS Inc.
The market structure covers the player categories, value chain, product ranges, and presence across products and end-user segments of the Sickle Cell Disease Diagnosis market. The report also provides a snapshot of market trends, key competition, with forecasts over the next 6 years, projected growth rates, and the principal factors promoting and hindering the growth market for Sickle Cell Disease Diagnosis, and analytics are derived from comprehensive research of primary and secondary sources.
Sickle Cell Disease Diagnosis Market Report Key Takeaways:
Detailed consideration of Sickle Cell Disease Diagnosis market-particular trends, drivers, constraints, opportunities, restraints, and major micro markets.
Comprehensive valuation of all prospects and threats in the In-depth study of industry strategies for growth of the Lemon Juice market-leading players.
Sickle Cell Disease Diagnosis major market procedures and latest innovations.
A favorable dive into the vigorous hi-tech and latest trends in the Sickle Cell Disease Diagnosis industry is notable in the market.
Conclusive study about the growth conspiracy of Sickle Cell Disease Diagnosis market for the upcoming years.
This report gives a complete view of the Sickle Cell Disease Diagnosis, providing knowledgeable insights to the users. The report is compiled and verified by industry experts focusing on important information users or customers require.
The researchers have studied government initiatives, marketing, social scenarios, and political environment that are likely to contribute to the growth of the regional markets. Analysis of various regional market trends, comprehensive data corresponding to the Sickle Cell Disease Diagnosis market size for the historical years, and estimates for the period from 2022 to 2028.
Buy a Premium report of Sickle Cell Disease Diagnosis Market for the Forecast Period 2022-2028@ https://www.vantagemarketresearch.com/buy-now/sickle-cell-disease-diagnosis-market-0209/0
Key Questions Answered in Sickle Cell Disease Diagnosis Market Report:
What is the market size and forecast of the global Sickle Cell Disease Diagnosis market?
What is the market share of the leading vendors in the Sickle Cell Disease Diagnosis market?
Which are the products/segments/applications/areas to invest in over the forecast period in the Sickle Cell Disease Diagnosis market?
What are the inhibiting factors and impact of COVID-19 shaping the global Sickle Cell Disease Diagnosis industry during the forecast period?
What is the competitive strategic window for opportunities in the Sickle Cell Disease Diagnosis market?
What modes and strategic moves are considered suitable for entering the global Sickle Cell Disease Diagnosis market?
What are the technology trends and regulatory frameworks in the global Sickle Cell Disease Diagnosis market?
Browse More Reports
Digital Therapeutics Market: https://www.vantagemarketresearch.com/industry-report/digital-therapeutics-market-1327
U.S. Education Market: https://aws.amazon.com/marketplace/pp/prodview-uopro4omv3hfw
Sickle Cell Disease Diagnosis Market: https://www.vantagemarketresearch.com/industry-report/sickle-cell-disease-diagnosis-market-0209
Polyimide Films Market: https://www.vantagemarketresearch.com/industry-report/polyimide-films-market-1863
Wheat Market: https://www.vantagemarketresearch.com/industry-report/wheat-market-1594
Electric Vehicle Market: https://aws.amazon.com/marketplace/pp/prodview-6eitzv5hwpkrq
Talent Management Software Market: https://www.globenewswire.com/en/news-release/2022/09/07/2511506/0/en/Talent-Management-Software-Market-Economy-Size-Expected-a-Growth-of-USD-13-4-Billion-by-2028-According-to-Vantage-Market-Research.html
Metal Powder Market: https://www.globenewswire.com/en/news-release/2022/11/14/2555273/0/en/Metal-Powder-Market-Size-Share-to-Surpass-8-3-Bn-by-2028-Vantage-Market-Research.html
Vantage Market Research provides accurate data and innovative corporate analysis, helping organizations of all sizes make informed decisions. We create innovative solutions for our customers, helping them solve various challenges in their business.
Eric Kunz
6218 Georgia Avenue NW Ste 1 - 564
Washington DC 20011-5125
United States Tel: +1 202 380 9727
Email: sales@vantagemarketresearch.com
Website: https://www.vantagemarketresearch.com/
This release was published on openPR.
Permanent link to this press release:
Copy
Please set a link in the press area of your homepage to this press release on openPR. openPR disclaims liability for any content contained in this release.
You can edit or delete your press release Sickle Cell Disease Diagnosis Market Size to Hit $7.9 Billion by 2028 | Sickle Cell Disease Diagnosis Industry Forecast Report here
News-ID: 2825713 • Views: …
More Releases from Vantage Market Research
The Global Vaccines Market: Driving Healthcare Innovation Through 2035
Key Takeaways
• The global vaccines market is experiencing robust growth, valued at USD 87.57 billion in 2024 and projected to reach USD 206.78 billion by 2035 with a CAGR of 9.80%
• mRNA technology breakthroughs are revolutionizing vaccine development, enabling faster production timelines and enhanced efficacy profiles
• Pediatric vaccines continue to dominate market share, while adult and travel immunization segments are emerging as high-growth opportunities
• Regulatory frameworks are evolving to accommodate…
Future Business Opportunities in Community-Based Elderly Care Service Market 202 …
The latest research study released by Vantage Market Research on "Community-Based Elderly Care Service Market" with 100+ pages of analysis on business strategy taken up by emerging industry players, geographical scope, market segments, product landscape and price, and cost structure. It also assists in market segmentation according to the industry's latest and upcoming trends to the bottom-most level, topographical markets, and key advancement from both market and technology-aligned perspectives. Each…
Forecasting the Future: Metaverse Game Development Service Market 2032 and Revol …
The business intelligence report on Metaverse Game Development Service Market defines the major trends determining this domain's growth with respect to competitive and geographical landscape. Moreover, the study covers the challenges that impede industry development and offers insights into untapped opportunities that will spur business expansion during the forecast period 2024-2032.
Learn how to build a strategy to implement and a business case. Learn about Metaverse Game Development Service market…
Empowering Growth: Horror Streaming Service Market 2024 and Industry Segments Ex …
Growing Demand of the Horror Streaming Service Market Overview 2024-2032:
The latest release from Vantage Market Research titled Horror Streaming Service Market Research Report 2024-2032 (by Product Type, End-User / Application, and Regions / Countries) provides an in-depth assessment of the Horror Streaming Service including key market trends, upcoming technologies, industry drivers, challenges, regulatory policies, key players company profiles, and strategies. Global Horror Streaming Service Market study with 100+ market data…
More Releases for Sickle
Sickle Cell Disease Treatment Market - Improving Quality of Life: Pioneering Sic …
Newark, New Castle, USA: The "Sickle Cell Disease Treatment Market" provides a value chain analysis of revenue for the anticipated period from 2022 to 2030. The report will include a full and comprehensive analysis of the business operations of all market leaders in this industry, as well as their in-depth market research, historical market development, and information about their market competitors
Sickle Cell Disease Treatment Market: https://www.growthplusreports.com/report/sickle-cell-disease-treatment-market/7808
This latest report researches the…
Sickle Cell Disease Treatment Market - Breaking the Chains of Sickle Cell: Pione …
Newark, New Castle, USA - new report, titled Sickle Cell Disease Treatment Market The report has been put together using primary and secondary research methodologies, which offer an accurate and precise understanding of the Sickle Cell Disease Treatment market. Analysts have used a top-down and bottom-up approach to evaluate the segments and provide a fair assessment of their impact on the global Sickle Cell Disease Treatment market. The report offers…
Global Sickle Cell Disease Treatment Market 2023: Sickle Cell Anaemia Anticipate …
The sickle cell disease treatment market is a segment of the broader pharmaceutical industry that is focused on developing treatments for sickle cell disease, a genetic disorder that affects the red blood cells. In 2022, the sickle cell disease treatment market is expected to continue to grow, driven by the increasing prevalence of the disease and the development of new treatments. The market is expected to be worth billions of…
Global Sickle Cell Disease Treatment Market 2023: Sickle Cell Anaemia Anticipate …
The sickle cell disease treatment market refers to the segment of the healthcare industry that produces and markets treatments for sickle cell disease (SCD), a genetic disorder that affects the production of hemoglobin in red blood cells. SCD can cause various complications, including pain, infections, and organ damage, and there is currently no cure for the disease. However, various treatments are available that can help manage the symptoms and improve…
Global Sickle Cell Disease Treatment Market 2023: Sickle Cell Anaemia Anticipate …
The sickle cell disease treatment market refers to the segment of the pharmaceuticals industry that deals with the production and sales of treatments for sickle cell disease. Sickle cell disease is a genetic blood disorder that causes red blood cells to become misshapen and form a sickle shape. This can lead to a range of complications, including anemia, chronic pain, and increased risk of infections.
The market for sickle cell disease…
Global Sickle Cell Disease Treatment Market 2023: Sickle Cell Anaemia Anticipate …
The Sickle Cell Disease Treatment Market is an emerging segment in the healthcare industry. This debilitating disorder affects millions of people around the world, with no known cure available. However, recent advances in research have improved the treatment options for those suffering from sickle cell disease. The Sickle Cell Disease Treatment Market is expected to experience significant growth over the coming years as treatments become more effective and accessible. Several…